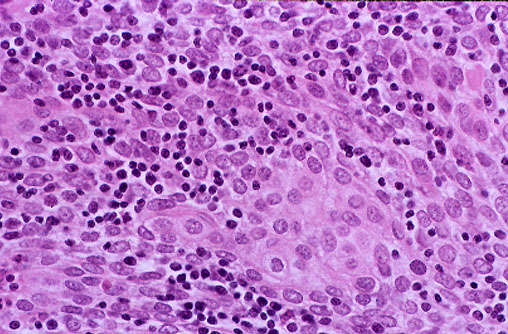

| At high magnification, the neoplastic epithelial elements of this thymoma display minimal pleomorphism, but this tumor was locally invasive and, therefore, a malignant thymoma. About 10% of thymomas are associated with systemic paraneoplastic syndromes including Graves disease, polymyositis, Cushing syndrome, and pernicious anemia. |
![]() |